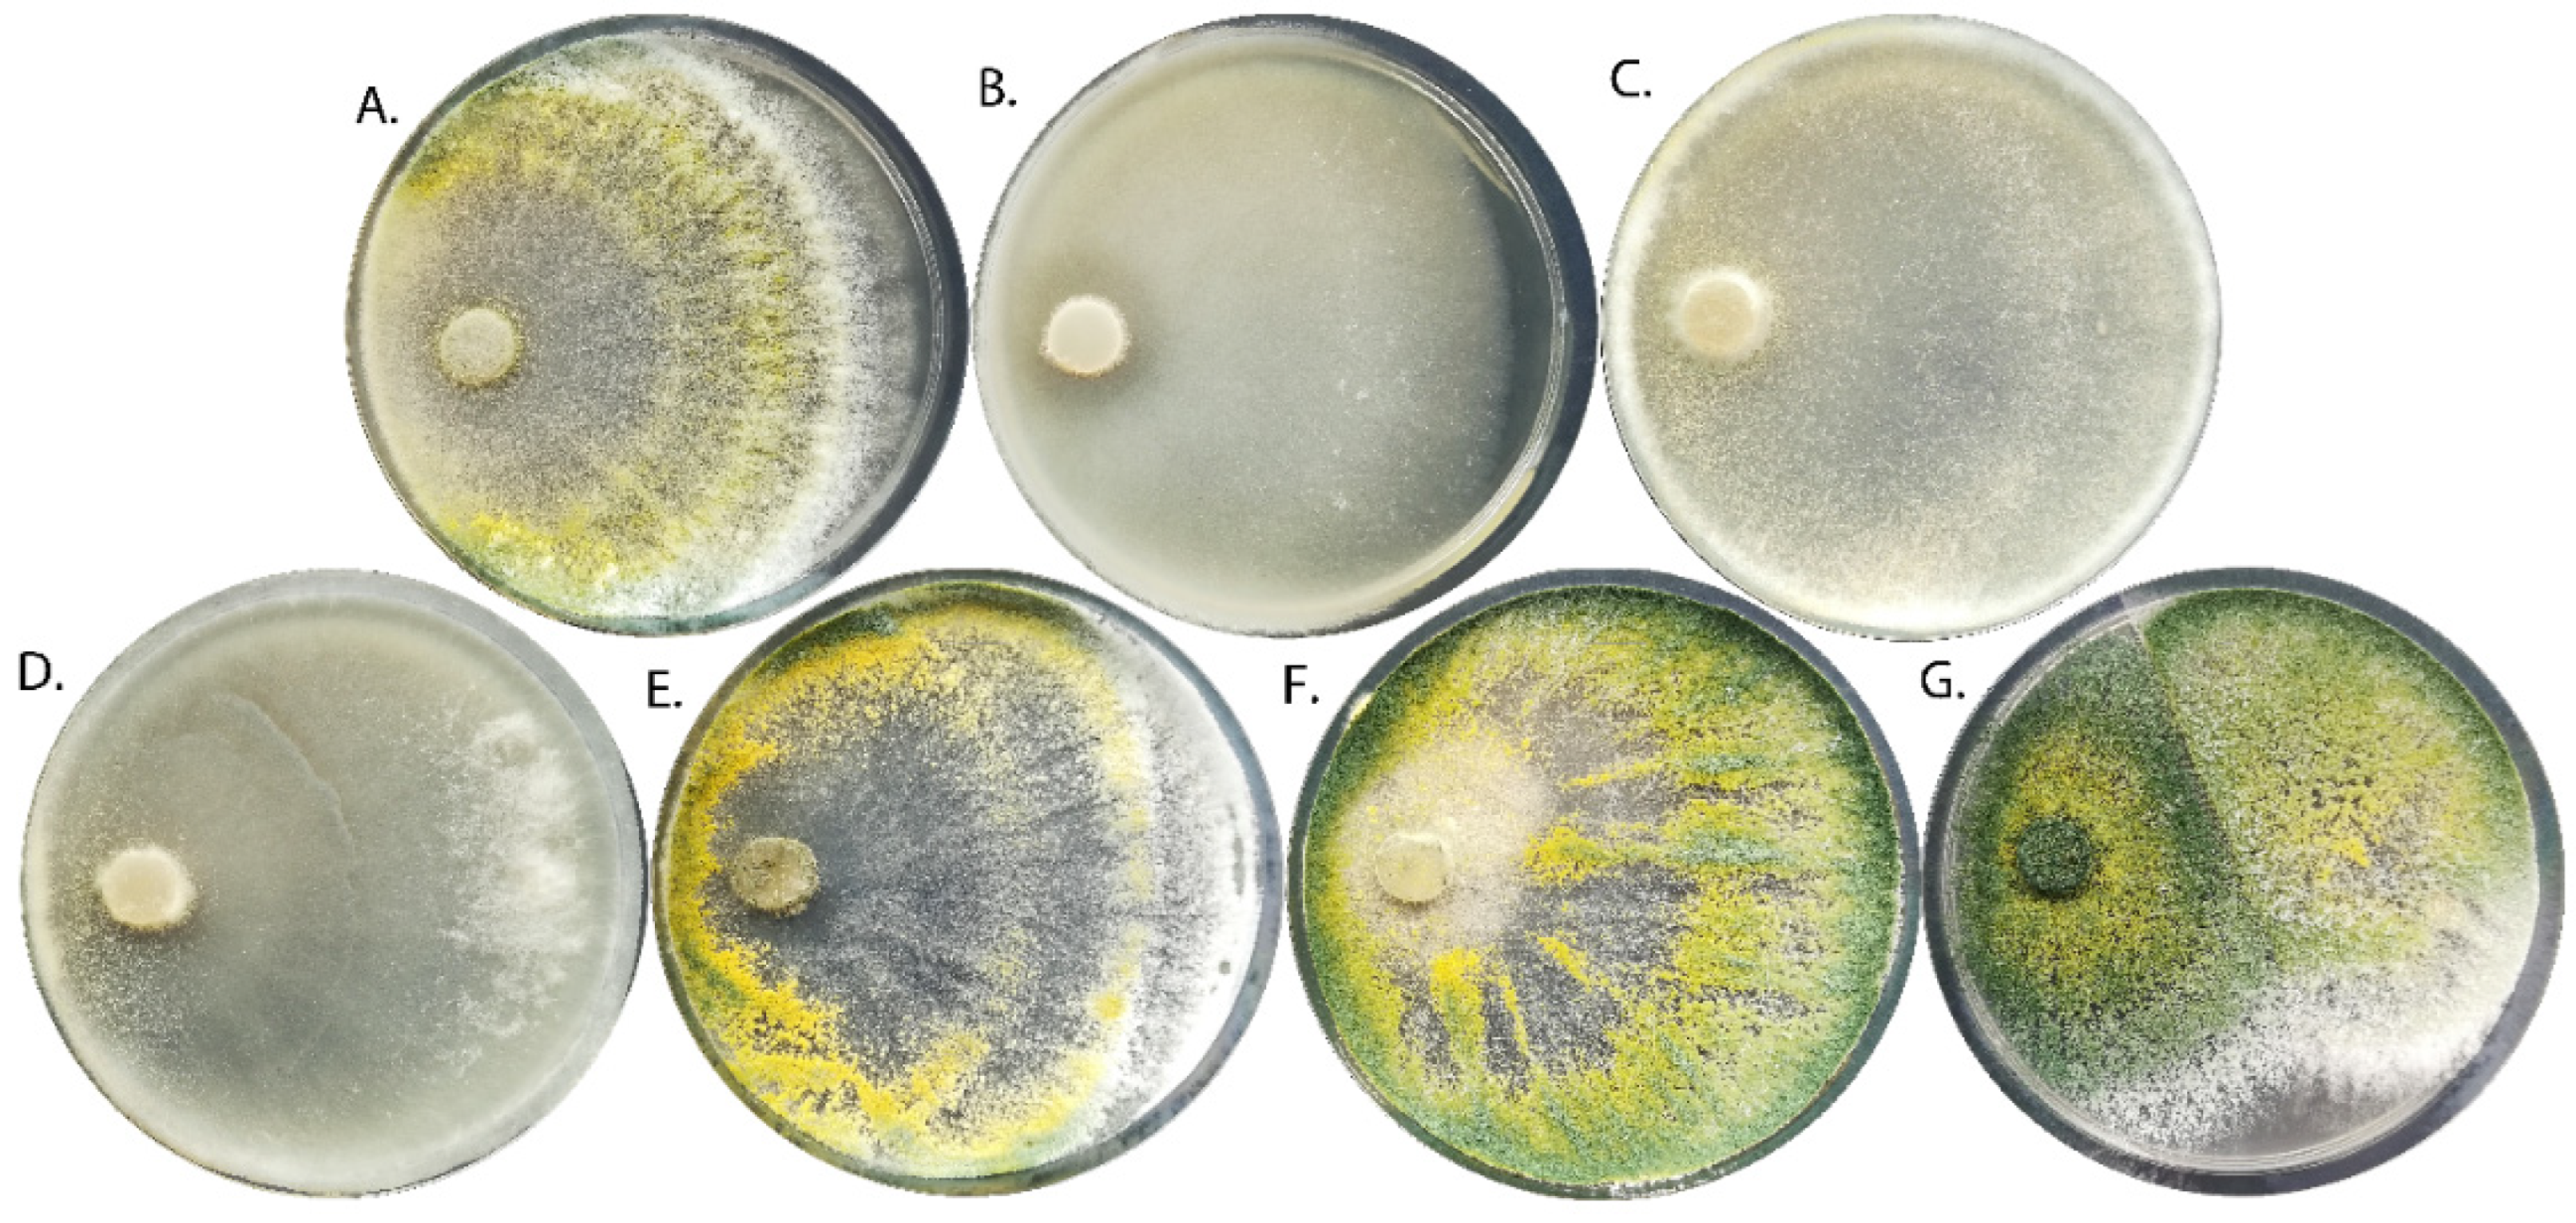
Ijms 24 15349 g001

Trichoderma viride Colonizes the Roots of Brassica napus L., Alters the Expression of Stress-Responsive Genes, and Increases the Yield of Canola under Field Conditions during Drought
Abstract
:1. Introduction
2. Results
2.1. Characterization of T. viride Strains
2.1.1. Morphology
2.1.2. Capacity to Synthesize Indole-3-Acetic Acid
2.1.3. Hydrolytic Activity
2.2. The Growth of B. napus Seedlings Inoculated with T. viride
2.3. The Colonization of B. napus Roots by T. viride
2.4. Analysis of BnMT and BnRSH Genes
2.4.1. In Silico Analysis of Gene Promoters
2.4.2. B. napus Metallothionein Gene Expression
2.4.3. B. napus RSH Genes Expression
2.5. Field Experiment
3. Discussion
4. Materials and Methods
4.1. Microbial and Plant Materials
4.2. Characterization of T. viride Isolates
4.2.1. Morphological Analysis
4.2.2. Evaluation of Capacity to Synthesize Indole-3-Acetic Acid
4.2.3. Assessment of Hydrolytic Activity
4.3. Microscopic Analysis
4.4. Analysis of Gene Expression
4.5. Field Experiment
4.6. Statistical Analysis
5. Conclusions
Author Contributions
Funding
Institutional Review Board Statement
Informed Consent Statement
Data Availability Statement
Conflicts of Interest
References
- Chmielewska, A.; Kozłowska, M.; Rachwał, D.; Wnukowski, P.; Amarowicz, R.; Nebesny, E.; Rosicka-Kaczmarek, J. Canola/rapeseed protein—Nutritional value, functionality and food application: A review. Crit. Rev. Food Sci. Nutr. 2021, 61, 3836–3856. [Google Scholar] [CrossRef] [PubMed]
- Zdziennicka, A.; Szymczyk, K.; Jańczuk, B.; Longwic, R.; Sander, P. Surface, volumetric, and wetting properties of oleic, linoleic, and linolenic acids with regards to application of canola oil in diesel engines. Appl. Sci. 2019, 9, 3445. [Google Scholar] [CrossRef]
- Lin, L.; Allemekinders, H.; Dansby, A.; Campbell, L.; Durance-Tod, S.; Berger, A.; Jones, P.J. Evidence of health benefits of canola oil. Nutr. Rev. 2013, 71, 370–385. [Google Scholar] [CrossRef]
- Fridrihsone, A.; Romagnoli, F.; Cabulis, U. Environmental life cycle assessment of rapeseed and rapeseed oil produced in Northern Europe: A Latvian case study. Sustainability 2020, 12, 5699. [Google Scholar] [CrossRef]
- Haile, G.G.; Tang, Q.; Li, W.; Liu, X.; Zhang, X. Drought: Progress in broadening its understanding. Wiley Interdiscip. Rev. Water 2020, 7, e1407. [Google Scholar] [CrossRef]
- Hasan, H.H.; Razali, S.F.M.; Muhammad, N.S.; Ahmad, A. Research trends of hydrological drought: A systematic review. Water 2019, 11, 2252. [Google Scholar] [CrossRef]
- Wu, W.; Ma, B.L. Assessment of canola crop lodging under elevated temperatures for adaptation to climate change. Agric. For. Meteorol. 2018, 248, 329–338. [Google Scholar] [CrossRef]
- Antoszewski, M.; Mierek-Adamska, A.; Dąbrowska, G.B. The importance of microorganisms for sustainable agriculture—A review. Metabolites 2022, 12, 1100. [Google Scholar] [CrossRef]
- Soudzilovskaia, N.A.; van Bodegom, P.M.; Terrer, C.; van’t Zelfde, M.; McCallum, I.; Luke McCormack, M.; Fisher, J.B.; Brundrett, M.C.; de Sá, N.C.; Tedersoo, L. Global mycorrhizal plant distribution linked to terrestrial carbon stocks. Nat. Commun. 2019, 10, 5077. [Google Scholar] [CrossRef]
- Tabrizi, L.; Mohammadi, S.; Delshad, M.; Moteshare Zadeh, B. Effect of arbuscular mycorrhizal fungi on yield and phytoremediation performance of pot marigold (Calendula officinalis L.) under heavy metals stress. Int. J. Phytoremediat. 2015, 17, 1244–1252. [Google Scholar] [CrossRef]
- Daei, G.; Ardekani, M.R.; Rejali, F.; Teimuri, S.; Miransari, M. Alleviation of salinity stress on wheat yield, yield components, and nutrient uptake using arbuscular mycorrhizal fungi under field conditions. J. Plant Physiol. 2009, 166, 617–625. [Google Scholar] [CrossRef] [PubMed]
- Mathur, S.; Tomar, R.S.; Jajoo, A. Arbuscular mycorrhizal fungi (AMF) protects photosynthetic apparatus of wheat under drought stress. Photosynth. Res. 2019, 139, 227–238. [Google Scholar] [CrossRef]
- Marulanda, A.; Porcel, R.; Barea, J.M.; Azcón, R. Drought tolerance and antioxidant activities in lavender plants colonized by native drought-tolerant or drought-sensitive Glomus species. Microb. Ecol. 2007, 54, 543–552. [Google Scholar] [CrossRef]
- Dąbrowska, G.B.; Baum, C.; Trejgell, A.; Hrynkiewicz, K. Impact of arbuscular mycorrhizal fungi on the growth and expression of gene encoding stress protein—Metallothionein BnMT2 in the non-host crop Brassica napus L. J. Plant Nutr. Soil Sci. 2014, 177, 459–467. [Google Scholar] [CrossRef]
- Santoyo, G.; Guzmán-Guzmán, P.; Isela Parra-Cota, F.; de los Santos-Villalobos, S.; del Carmen Orozco-Mosqueda, M.; Glick, B.R.; Flores-Félix, D.; Velazquez, E.; González-Andrés, F. Plant growth stimulation by microbial consortia. Agronomy 2021, 11, 219. [Google Scholar] [CrossRef]
- Mukherjee, R.K.; Kumar, V.; Roy, K. Chemometric modeling of plant protection products (PPPs) for the prediction of acute contact toxicity against honey bees (A. mellifera): A 2D-QSAR approach. J. Hazard. Mater. 2022, 423, 127230. [Google Scholar] [CrossRef]
- Rani, L.; Thapa, K.; Kanojia, N.; Sharma, N.; Singh, S.; Grewal, A.S.; Srivastav, A.L.; Kaushal, J. An extensive review on the consequences of chemical pesticides on human health and environment. J. Clean. Prod. 2021, 283, 124657. [Google Scholar] [CrossRef]
- De Souza, R.M.; Seibert, D.; Quesada, H.B.; de Jesus Bassetti, F.; Fagundes-Klen, M.R.; Bergamasco, R. Occurrence, impacts and general aspects of pesticides in surface water: A review. Process Saf. Environ. Prot. 2020, 135, 22–37. [Google Scholar] [CrossRef]
- Matarczyk, J.A.; Willis, A.J.; Vranjic, J.A.; Ash, J.E. Herbicides, weeds and endangered species: Management of bitou bush (Chrysanthemoides monilifera ssp. rotundata) with glyphosate and impacts on the endangered shrub, Pimelea spicata. Biol. Conserv. 2002, 108, 133–141. [Google Scholar]
- Weltje, L.; Simpson, P.; Gross, M.; Crane, M.; Wheeler, J.R. Comparative acute and chronic sensitivity of fish and amphibians: A critical review of data. Environ. Toxicol. Chem. 2013, 32, 984–994. [Google Scholar] [CrossRef] [PubMed]
- Tudi, M.; Ruan, H.D.; Wang, L.; Lyu, J.; Sadler, R.; Connell, D.; Chu, C.; Phung, D.T. Agriculture development, pesticide application and its impact on the environment. Int. J. Environ. Res. Public Health 2021, 18, 1112. [Google Scholar] [CrossRef] [PubMed]
- Schnitkey, G.; Paulson, N.; Zulauf, C.; Swanson, K.; Baltz, J. Fertilizer Prices, Rates, and Costs for 2023; University of Illinois Urbana: Champaign, IL, USA, 2022; Volume 12. [Google Scholar]
- Vinayarani, G.; Prakash, H.S. Fungal endophytes of turmeric (Curcuma longa L.) and their biocontrol potential against pathogens Pythium aphanidermatum and Rhizoctonia solani. World J. Microbiol. Biotechnol. 2018, 34, 49. [Google Scholar] [CrossRef] [PubMed]
- Nuangmek, W.; Aiduang, W.; Kumla, J.; Lumyong, S.; Suwannarach, N. Evaluation of a newly identified endophytic fungus, Trichoderma phayaoense for plant growth promotion and biological control of gummy stem blight and wilt of muskmelon. Front. Microbiol. 2021, 12, 410. [Google Scholar] [CrossRef]
- Janowska, B.; Andrzejak, R.; Kosiada, T. The influence of fungi of the Trichoderma genus on the flowering of Freesia refracta Klatt “Argentea” in winter. Hortic. Sci. 2020, 47, 203–210. [Google Scholar] [CrossRef]
- Znajewska, Z.; Dąbrowska, G.B.; Narbutt, O. Trichoderma viride strains stimulating the growth and development of winter rapeseed (Brassica napus L.). Prog. Plant Prot. 2018, 58, 264–269. [Google Scholar]
- Turkan, S.; Mierek-Adamska, A.; Kulasek, M.; Konieczna, W.B.; Dąbrowska, G.B. New seed coating containing Trichoderma viride with anti-pathogenic properties. PeerJ 2023, 11, e15392. [Google Scholar] [CrossRef] [PubMed]
- Qi, W.; Zhao, L. Study of the siderophore-producing Trichoderma asperellum Q1 on cucumber growth promotion under salt stress. J. Basic Microbiol. 2013, 53, 355–364. [Google Scholar] [CrossRef] [PubMed]
- Shukla, N.; Awasthi, R.P.; Rawat, L.; Kumar, J. Biochemical and physiological responses of rice (Oryza sativa L.) as influenced by Trichoderma harzianum under drought stress. Plant Physiol. Biochem. 2012, 54, 78–88. [Google Scholar] [CrossRef]
- Illescas, M.; Pedrero-Méndez, A.; Pitorini-Bovolini, M.; Hermosa, R.; Monte, E. Phytohormone production profiles in Trichoderma species and their relationship to wheat plant responses to water stress. Pathogens 2021, 10, 991. [Google Scholar] [CrossRef]
- Mastouri, F.; Björkman, T.; Harman, G.E. Seed treatment with Trichoderma harzianum alleviates biotic, abiotic, and physiological stresses in germinating seeds and seedlings. Phytopathology 2010, 100, 1213–1221. [Google Scholar] [CrossRef]
- Contreras-Cornejo, H.A.; Macías-Rodríguez, L.; Cortés-Penagos, C.; López-Bucio, J. Trichoderma virens, a plant beneficial fungus, enhances biomass production and promotes lateral root growth through an auxin-dependent mechanism in Arabidopsis. Plant Physiol. 2009, 149, 1579–1592. [Google Scholar] [CrossRef]
- Li, R.X.; Cai, F.; Pang, G.; Shen, Q.R.; Li, R.; Chen, W. Solubilisation of phosphate and micronutrients by Trichoderma harzianum and its relationship with the promotion of tomato plant growth. PLoS ONE 2015, 10, e0130081. [Google Scholar] [CrossRef]
- Viterbo, A.; Landau, U.; Kim, S.; Chernin, L.; Chet, I. Characterization of ACC deaminase from the biocontrol and plant growth-promoting agent Trichoderma asperellum T203. FEMS Microbiol. Lett. 2010, 305, 42–48. [Google Scholar] [CrossRef]
- Shi, M.; Chen, L.; Wang, X.W.; Zhang, T.; Zhao, P.B.; Song, X.Y.; Sun, C.Y.; Chen, X.L.; Zhou, B.C.; Zhang, Y.Z. Antimicrobial peptaibols from Trichoderma pseudokoningii induce programmed cell death in plant fungal pathogens. Microbiology 2012, 158, 166–175. [Google Scholar] [CrossRef] [PubMed]
- Leonetti, P.; Zonno, M.C.; Molinari, S.; Altomare, C. Induction of SA-signaling pathway and ethylene biosynthesis in Trichoderma harzianum-treated tomato plants after infection of the root-knot nematode Meloidogyne incognita. Plant Cell Rep. 2017, 36, 621–631. [Google Scholar] [CrossRef]
- Shoresh, M.; Yedidia, I.; Chet, I. Involvement of jasmonic acid/ethylene signaling pathway in the systemic resistance induced in cucumber by Trichoderma asperellum T203. Phytopathology 2007, 95, 76–84. [Google Scholar] [CrossRef] [PubMed]
- Shoresh, M.; Harman, G.E. The molecular basis of shoot responses of maize seedlings to Trichoderma harzianum T22 inoculation of the root: A proteomic approach. Plant Physiol. 2008, 147, 2147–2163. [Google Scholar] [CrossRef]
- Nogueira-Lopez, G.; Greenwood, D.R.; Middleditch, M.; Winefield, C.; Eaton, C.; Steyaert, J.M.; Mendoza-Mendoza, A. The apoplastic secretome of Trichoderma virens during interaction with maize roots shows an inhibition of plant defence and scavenging oxidative stress secreted proteins. Front. Plant Sci. 2018, 9, 409. [Google Scholar] [CrossRef]
- Dąbrowska, G.B.; Mierek-Adamska, A.; Goc, A. Plant metallothioneins: Putative functions identified by promoter analysis in silico. Acta Biol. Cracoviensia 2012, 54, 109–120. [Google Scholar] [CrossRef]
- Gao, C.; Gao, K.; Yang, H.; Ju, T.; Zhu, J.; Tang, Z.; Zhao, L.; Chen, Q. Genome-wide analysis of metallothionein gene family in maize to reveal its role in development and stress resistance to heavy metal. Biol. Res. 2022, 55, 1. [Google Scholar] [CrossRef]
- Yu, Q.; He, L.; Huo, C.; Jiang, X.; Chen, H.; Wang, R.; Tang, M.; Dong, L.; Chen, J.; Li, Y.; et al. Genome-wide identification and expression analysis of heavy metal stress–responsive metallothionein family genes in Nicotiana tabacum. Plant Mol. Biol. Rep. 2021, 39, 443–454. [Google Scholar] [CrossRef]
- Konieczna, W.; Warchoł, M.; Mierek-Adamska, A.; Skrzypek, E.; Waligórski, P.; Piernik, A.; Dąbrowska, G.B. Changes in physio-biochemical parameters and expression of metallothioneins in Avena sativa L. in response to drought. Sci. Rep. 2023, 13, 2486. [Google Scholar] [CrossRef] [PubMed]
- Pan, Y.; Zhu, M.; Wang, S.; Ma, G.; Huang, X.; Qiao, C.; Wang, R.; Xu, X.; Liang, Y.; Lu, K.; et al. Genome-wide characterization and analysis of metallothionein family genes that function in metal stress tolerance in Brassica napus L. Int. J. Mol. Sci. 2018, 19, 2181. [Google Scholar] [CrossRef] [PubMed]
- Ziller, A.; Fraissinet-Tachet, L. Metallothionein diversity and distribution in the tree of life: A multifunctional protein. Metallomics 2018, 10, 1549–1559. [Google Scholar] [CrossRef]
- Liu, S.X.; Fabisiak, J.P.; Tyurin, V.A.; Borisenko, G.G.; Pitt, B.R.; Lazo, J.S.; Kagan, V.E. Reconstitution of apo-superoxide dismutase by nitric oxide-induced copper transfer from metallothioneins. Chem. Res. Toxicol. 2000, 13, 922–931. [Google Scholar] [CrossRef]
- Saeed-Ur, R.; Khalid, M.; Hui, N.; Kayani, S.I.; Tang, K. Diversity and versatile functions of metallothioneins produced by plants: A review. Pedosphere 2020, 30, 577–588. [Google Scholar] [CrossRef]
- Yang, Z.; Wu, Y.; Li, Y.; Ling, H.Q.; Chu, C. OsMT1a, a type 1 metallothionein, plays the pivotal role in zinc homeostasis and drought tolerance in rice. Plant Mol. Biol. 2009, 70, 219–229. [Google Scholar] [CrossRef]
- Xue, T.; Li, X.; Zhu, W.; Wu, C.; Yang, G.; Zheng, C. Cotton metallothionein GhMT3a, a reactive oxygen species scavenger, increased tolerance against abiotic stress in transgenic tobacco and yeast. J. Exp. Bot. 2009, 60, 339–349. [Google Scholar] [CrossRef]
- Seki, M.; Narusaka, M.; Ishida, J.; Nanjo, T.; Fujita, M.; Oono, Y.; Kamiya, A.; Nakajima, M.; Enju, A.; Sakurai, T.; et al. Monitoring the expression profiles of 7000 Arabidopsis genes under drought, cold and high-salinity stresses using a full-length cDNA microarray. Plant J. 2002, 31, 279–292. [Google Scholar] [CrossRef]
- Jaiswal, P.S.; Mittal, N.; Randhawa, G.S. Cyamopsis tetragonoloba type 1 metallothionein (CtMT1) gene is upregulated under drought stress and its protein product has an additional C-X-C motif and unique metal binding pattern. Int. J. Biol. Macromol. 2018, 119, 1324–1334. [Google Scholar] [CrossRef]
- Collett, H.; Shen, A.; Gardner, M.; Farrant, J.M.; Denby, K.J.; Illing, N. Towards transcript profiling of desiccation tolerance in Xerophyta humilis: Construction of a normalized 11 k X. humilis cDNA set and microarray expression analysis of 424 cDNAs in response to dehydration. Physiol. Plant 2004, 122, 39–53. [Google Scholar] [CrossRef]
- Takahashi, K.; Kasai, K.; Ochi, K. Identification of the bacterial alarmone guanosine 5′-diphosphate 3′-diphosphate (ppGpp) in plants. Proc. Natl. Acad. Sci. USA 2004, 101, 4320–4324. [Google Scholar] [CrossRef] [PubMed]
- Prusińska, J.M.; Boniecka, J.; Dąbrowska, G.B.; Goc, A. Identification and characterization of the Ipomoea nil RelA/SpoT Homologs (InRSHs) and potential directions of their transcriptional regulation. Plant Sci. 2019, 284, 161–176. [Google Scholar] [CrossRef]
- Boniecka, J.; Prusińska, J.; Dąbrowska, G.B.; Goc, A. Within and beyond the stringent response-RSH and (p)ppGpp in plants. Planta 2017, 246, 817–842. [Google Scholar] [CrossRef]
- Dąbrowska, G.B.; Turkan, S.; Tylman-Mojżeszek, W.; Mierek-Adamska, A. In silico study of the rsh (Rela/spot homologs) gene family and expression analysis in response to pgpr bacteria and salinity in Brassica napus. Int. J. Mol. Sci. 2021, 22, 10666. [Google Scholar] [CrossRef] [PubMed]
- Tozawa, Y.; Nozawa, A.; Kanno, T.; Narisawa, T.; Masuda, S.; Kasai, K.; Nanamiya, H. Calcium-activated (p)ppGpp synthetase in chloroplasts of land plants. J. Biol. Chem. 2007, 282, 35536–35545. [Google Scholar] [CrossRef] [PubMed]
- Shin, J.; Singal, B.; Grüber, A.; Wong, D.M.K.; Ragunathan, P.; Grüber, G. Atomic structure of the regulatory TGS domain of Rel protein from Mycobacterium tuberculosis and its interaction with deacylated tRNA. FEBS Lett. 2021, 595, 3006–3018. [Google Scholar] [CrossRef]
- Ito, K.; Ito, D.; Goto, M.; Suzuki, S.; Masuda, S.; Iba, K.; Kusumi, K. Regulation of ppGpp synthesis and its impact on chloroplast biogenesis during early leaf development in rice. Plant Cell Physiol. 2022, 63, 919–931. [Google Scholar] [CrossRef]
- Field, B. Green magic: Regulation of the chloroplast stress response by (p)ppGpp in plants and algae. J. Exp. Bot. 2018, 69, 2797–2807. [Google Scholar] [CrossRef]
- Sugliani, M.; Abdelkefi, H.; Ke, H.; Bouveret, E.; Robaglia, C.; Caffarri, S.; Field, B. An ancient bacterial signaling pathway regulates chloroplast function to influence growth and development in Arabidopsis. Plant Cell 2016, 28, 661–679. [Google Scholar] [CrossRef]
- Honoki, R.; Ono, S.; Oikawa, A.; Saito, K.; Masuda, S. Significance of accumulation of the alarmone (p)ppGpp in chloroplasts for controlling photosynthesis and metabolite balance during nitrogen starvation in Arabidopsis. Photosynth. Res. 2018, 135, 299–308. [Google Scholar] [CrossRef] [PubMed]
- Maekawa, M.; Honoki, R.; Ihara, Y.; Sato, R.; Oikawa, A.; Kanno, Y.; Ohta, H.; Seo, M.; Saito, K.; Masuda, S. Impact of the plastidial stringent response in plant growth and stress responses. Nat. Plant. 2015, 1, 15167. [Google Scholar] [CrossRef] [PubMed]
- Abdelkefi, H.; Sugliani, M.; Ke, H.; Harchouni, S.; Soubigou-Taconnat, L.; Citerne, S.; Mouille, G.; Fakhfakh, H.; Robaglia, C.; Field, B. Guanosine tetraphosphate modulates salicylic acid signalling and the resistance of Arabidopsis thaliana to Turnip mosaic virus. Mol. Plant Pathol. 2018, 19, 634–646. [Google Scholar] [CrossRef]
- Masuda, S.; Mizusawa, K.; Narisawa, T.; Tozawa, Y.; Ohta, H.; Takamiya, K.I. The bacterial stringent response, conserved in chloroplasts, controls plant fertilization. Plant Cell Physiol. 2008, 49, 135–141. [Google Scholar] [CrossRef]
- Lescot, M.; Déhais, P.; Thijs, G.; Marchal, K.; Moreau, Y.; Van De Peer, Y.; Rouzé, P.; Rombauts, S. PlantCARE, a database of plant cis-acting regulatory elements and a portal to tools for in silico analysis of promoter sequences. Nucleic Acids Res. 2002, 30, 325–327. [Google Scholar] [CrossRef]
- Malik, N.A.A.; Kumar, I.S.; Nadarajah, K. Elicitor and receptor molecules: Orchestrators of plant defense and immunity. Int. J. Mol. Sci. 2020, 21, 963. [Google Scholar]
- Mohanram, S.; Kumar, P. Rhizosphere microbiome: Revisiting the synergy of plant-microbe interactions. Ann. Microbiol. 2019, 69, 307–320. [Google Scholar] [CrossRef]
- Zhang, K.; Bonito, G.; Hsu, C.M.; Hameed, K.; Vilgalys, R.; Liao, H.L. Mortierella elongata increases plant biomass among non-leguminous crop species. Agronomy 2020, 10, 754. [Google Scholar] [CrossRef]
- Dangl, J.L.; Horvath, D.M.; Staskawicz, B.J. Pivoting the plant immune system from dissection to deployment. Science 2013, 341, 746–751. [Google Scholar] [CrossRef]
- Romero, F.M.; Marina, M.; Pieckenstain, F.L.; Rossi, F.R.; Gonzalez, M.E.; Vignatti, P.; Gárriz, A. Gaining insight into plant responses to beneficial and pathogenic microorganisms using metabolomic and transcriptomic approaches. In Metabolic Engineering for Bioactive Compounds: Strategies and Processes; Springer: Berlin/Heidelberg, Germany, 2017; pp. 113–140. [Google Scholar]
- Brotman, Y.; Briff, E.; Viterbo, A.; Chet, I. Role of swollenin, an expansin-like protein from Trichoderma, in plant root colonization. Plant Physiol. 2008, 147, 779–789. [Google Scholar] [CrossRef]
- Engelberth, J.; Koch, T.; Schüler, G.; Bachmann, N.; Rechtenbach, J.; Boland, W. Ion channel-forming alamethicin is a potent elicitor of volatile biosynthesis and tendril coiling. Cross talk between Jasmonate and salicylate signaling in lima bean. Plant Physiol. 2001, 125, 369–377. [Google Scholar] [CrossRef]
- Martinez, C.; Blanc, F.; le Claire, E.; Besnard, O.; Nicole, M.; Baccou, J.C. Salicylic acid and ethylene pathways are differentially activated in melon cotyledons by active or heat-denatured cellulase from Trichoderma longibrachiatum. Plant Physiol. 2001, 127, 334–344. [Google Scholar] [CrossRef] [PubMed]
- Rotblat, B.; Enshell-Seijffers, D.; Gershoni, J.M.; Schuster, S.; Avni, A. Identification of an essential component of the elicitation active site of the EIX protein elicitor. Plant J. 2002, 32, 1049–1055. [Google Scholar] [CrossRef] [PubMed]
- Eugenia, M.D.; Hermosa, R.; Ambrosino, P.; Cardoza, R.E.; Gutiérrez, S.; Lorito, M.; Monte, E. The ThPG1 endopolygalacturonase Is required for the Trichoderma harzianum-plant beneficial interaction. Mol. Plant-Microbe Interact. 2009, 22, 1021–1031. [Google Scholar]
- Tymiński, Ł.P.; Znajewska, Z.; Dąbrowska, G.B. Characteristics and functions of hydrophobins and their use in manifold industries. Adv. Microbiol. 2018, 57, 374–384. [Google Scholar] [CrossRef]
- Viterbo, A.; Chet, I. TasHyd1, a new hydrophobin gene from the biocontrol agent Trichoderma asperellum, is involved in plant root colonization. Mol. Plant Pathol. 2006, 7, 249–258. [Google Scholar] [CrossRef] [PubMed]
- Yedidia, I.; Benhamou, N.; Chet, I. Induction of defense responses in cucumber plants (Cucumis sativus L.) by the biocontrol agent Trichoderma harzianum. Appl. Environ. Microbiol. 1999, 65, 1061–1070. [Google Scholar] [CrossRef]
- Zhai, X.; Jia, M.; Chen, L.; Zheng, C.J.; Rahman, K.; Han, T.; Qin, L.P. The regulatory mechanism of fungal elicitor-induced secondary metabolite biosynthesis in medical plants. Crit. Rev. Microbiol. 2017, 43, 238–261. [Google Scholar] [CrossRef] [PubMed]
- Agostini, R.B.; Ariel, F.; Rius, S.P.; Vargas, W.A.; Campos-Bermudez, V.A. Trichoderma root colonization triggers epigenetic changes in jasmonic and salicylic acid pathway-related genes. J. Exp. Bot. 2022, 74, 2016–2028. [Google Scholar] [CrossRef]
- Ren, Y.; Liu, Y.; Chen, H.; Li, G.; Zhang, X.; Zhao, J. Type 4 metallothionein genes are involved in regulating Zn ion accumulation in late embryo and in controlling early seedling growth in Arabidopsis. Plant Cell Environ. 2012, 35, 770–789. [Google Scholar] [CrossRef]
- Dąbrowska, G.; Mierek-Adamska, A.; Goc, A. Characterisation of Brassica napus L. metallothionein genes (BnMTs) expression in organs and during seed germination. Aust. J. Crop Sci. 2013, 7, 1324–1332. [Google Scholar]
- Schiller, M.; Hegelund, J.N.; Pedas, P.; Kichey, T.; Laursen, K.H.; Husted, S.; Schjoerring, J.K. Barley metallothioneins differ in ontogenetic pattern and response to metals. Plant Cell Environ. 2014, 37, 353–367. [Google Scholar] [CrossRef] [PubMed]
- Guo, W.J.; Bundithya, W.; Goldsbrough, P.B. Characterization of the Arabidopsis metallothionein gene family: Tissue-specific expression and induction during senescence and in response to copper. New Phytol. 2003, 159, 369–381. [Google Scholar] [CrossRef] [PubMed]
- Gautam, N.; Verma, P.K.; Verma, S.; Tripathi, R.D.; Trivedi, P.K.; Adhikari, B.; Chakrabarty, D. Genome-wide identification of rice class i metallothionein gene: Tissue expression patterns and induction in response to heavy metal stress. Funct. Integr. Genom. 2012, 12, 635–647. [Google Scholar] [CrossRef] [PubMed]
- Liu, J.; Shi, X.; Qian, M.; Zheng, L.; Lian, C.; Xia, Y.; Shen, Z. Copper-induced hydrogen peroxide upregulation of a metallothionein gene, OsMT2c, from Oryza sativa L. confers copper tolerance in Arabidopsis thaliana. J. Hazard. Mater. 2015, 294, 99–108. [Google Scholar] [CrossRef]
- Li, Z.; Zhang, Y.; Zhang, X.; Peng, Y.; Merewitz, E.; Ma, X.; Huang, L.; Yan, Y. The alterations of endogenous polyamines and phytohormones induced by exogenous application of spermidine regulate antioxidant metabolism, metallothionein and relevant genes conferring drought tolerance in white clover. Environ. Exp. Bot. 2016, 124, 22–38. [Google Scholar] [CrossRef]
- Ahn, Y.O.; Kim, S.H.; Lee, J.; Ran Kim, H.; Lee, H.S.; Kwak, S.S. Three Brassica rapa metallothionein genes are differentially regulated under various stress conditions. Mol. Biol. Rep. 2012, 39, 2059–2067. [Google Scholar] [CrossRef]
- Hrynkiewicz, K.; Dabrowska, G.; Baum, C.; Niedojadlo, K.; Leinweber, P. Interactive and single effects of ectomycorrhiza formation and Bacillus cereus on metallothionein MT1 expression and phytoextraction of Cd and Zn by willows. Water Air Soil. Pollut. 2012, 223, 957–968. [Google Scholar] [CrossRef]
- Mirzahossini, Z.; Shabani, L.; Sabzalian, M.R.; Sharifi-Tehrani, M. ABC transporter and metallothionein expression affected by Ni and Epichloe endophyte infection in tall fescue. Ecotoxicol. Environ. Saf. 2015, 120, 13–19. [Google Scholar] [CrossRef]
- Zhou, Y.; Liu, J.; Liu, S.; Jiang, L.; Hu, L. Identification of the metallothionein gene family from cucumber and functional characterization of CsMT4 in Escherichia coli under salinity and osmotic stress. 3 Biotech 2019, 9, 394. [Google Scholar] [CrossRef]
- Konieczna, W.; Mierek-Adamska, A.; Warchoł, M.; Skrzypek, E.; Dąbrowska, G.B. The involvement of metallothioneins and stress markers in response to osmotic stress in Avena sativa L. J. Agron. Crop Sci. 2023, 209, 371–389. [Google Scholar] [CrossRef]
- Dunaeva, M.; Adamska, I. Identification of genes expressed in response to light stress in leaves of Arabidopsis thaliana using RNA differential display. Eur. J. Biochem. 2001, 268, 5521–5529. [Google Scholar] [CrossRef] [PubMed]
- Choi, D.; Kim, H.M.; Yun, H.K.; Park, J.A.; Kim, W.T.; Bok, S.H. Molecular cloning of a metallothionein-like gene from Nicotiana glutinosa L. and its induction by wounding and tobacco mosaic virus infection. Plant Physiol. 1996, 112, 353–359. [Google Scholar] [CrossRef]
- Butt, A.; Mousley, C.; Morris, K.; Beynon, J.; Can, C.; Holub, E.; Greenberg, J.T.; Buchanan-Wollaston, V. Differential expression of a senescence-enhanced metallothionein gene in Arabidopsis in response to isolates of Peronospora parasitica and Pseudomonas syringae. Plant J. 1998, 16, 209–221. [Google Scholar] [CrossRef]
- Dąbrowska, G.B.; Garstecka, Z.; Trejgell, A.; Dąbrowski, H.P.; Konieczna, W.; Szyp-Borowska, I. The impact of forest fungi on promoting growth and development of Brassica napus L. Agronomy 2021, 11, 2475. [Google Scholar] [CrossRef]
- Cashel, M.; Gallant, J. Two compounds implicated in the function of the RC gene of Escherichia coli. Nature 1969, 221, 838–841. [Google Scholar] [CrossRef]
- Wang, J.; Tian, Y.; Zhou, Z.; Zhang, L.; Zhang, W.; Lin, M.; Chen, M. Identification and functional analysis of RelA/SpoT Homolog (RSH) genes in Deinococcus radiodurans. J. Microbiol. Biotechnol. 2016, 26, 2106–2115. [Google Scholar] [CrossRef] [PubMed]
- Gan, H.M.; Buckley, L.; Szegedi, E.; Hudson, A.O.; Savka, M.A. Identification of an rsh gene from a Novosphingobium sp. necessary for quorum-sensing signal accumulation. J. Bacteriol. 2009, 191, 2551–2560. [Google Scholar] [CrossRef]
- Geiger, T.; Goerke, C.; Fritz, M.; Schäfer, T.; Ohlsen, K.; Liebeke, M.; Lalk, M.; Wolz, C. Role of the (p)ppGpp synthase RSH, a RelA/SpoT homolog, in stringent response and virulence of Staphylococcus aureus. Infect. Immun. 2010, 78, 1873–1883. [Google Scholar] [CrossRef] [PubMed]
- Sun, D.; Lee, G.; Lee, J.H.; Kim, H.Y.; Rhee, H.W.; Park, S.Y.; Kim, K.J.; Kim, Y.; Kim, B.Y.; Hong, J.I.; et al. A metazoan ortholog of SpoT hydrolyzes ppGpp and functions in starvation responses. Nat. Struct. Mol. Biol. 2010, 17, 1188–1194. [Google Scholar] [CrossRef] [PubMed]
- Van der Biezen, E.A.; Sun, J.; Coleman, M.J.; Bibb, M.J.; Jones, J.D.G. Arabidopsis RelA/SpoT homologs implicate (p)ppGpp in plant signaling. Proc. Natl. Acad. Sci. USA 2000, 97, 3747–3752. [Google Scholar] [CrossRef] [PubMed]
- Givens, R.M.; Lin, M.H.; Taylor, D.J.; Mechold, U.; Berry, J.O.; Hernandez, V.J. Inducible expression, enzymatic activity, and origin of higher plant homologues of bacrterial RelA/SpoT stress proteins in Nicotiana tabacum. J. Biol. Chem. 2004, 279, 7495–7504. [Google Scholar] [CrossRef]
- Kim, T.H.; Ok, S.H.; Kim, D.; Suh, S.C.; Byun, M.O.; Shin, J.S. Molecular characterization of a biotic and abiotic stress resistance-related gene RelA/SpoT homologue (PepRSH) from pepper. Plant Sci. 2009, 176, 635–642. [Google Scholar] [CrossRef]
- Romand, S.; Abdelkefi, H.; Lecampion, C.; Belaroussi, M.; Dussenne, M.; Ksas, B.; Citerne, S.; Caius, J.; D’Alessandro, S.; Fakhfakh, H.; et al. A guanosine tetraphosphate (ppGpp) mediated brake on photosynthesis is required for acclimation to nitrogen limitation in Arabidopsis. Elife 2022, 11, 75041. [Google Scholar] [CrossRef]
- Li, H.; Nian, J.; Fang, S.; Guo, M.; Huang, X.; Zhang, F.; Wang, Q.; Zhang, J.; Bai, J.; Dong, G.; et al. Regulation of nitrogen starvation responses by the alarmone (p)ppGpp in rice. J. Genet. Genom. 2022, 49, 469–480. [Google Scholar] [CrossRef]
- Szymańska, S.; Dąbrowska, G.B.; Tyburski, J.; Niedojadło, K.; Piernik, A.; Hrynkiewicz, K. Boosting the Brassica napus L. tolerance to salinity by the halotolerant strain Pseudomonas stutzeri ISE12. Environ. Exp. Bot. 2019, 163, 55–68. [Google Scholar] [CrossRef]
- Azarmi, R.; Hajieghrari, B.; Giglou, A. Effect of Trichoderma isolates on tomato seedling growth response and nutrient uptake. Afr. J. Biotechnol. 2013, 10, 5850–5855. [Google Scholar]
- Shukla, N.; Awasthi, R.P.; Rawat, L.; Kumar, J. Seed biopriming with drought tolerant isolates of Trichoderma harzianum promote growth and drought tolerance in Triticum aestivum. Ann. Appl. Biol. 2015, 166, 171–182. [Google Scholar] [CrossRef]
- Guler, N.S.; Pehlivan, N.; Karaoglu, S.A.; Guzel, S.; Bozdeveci, A. Trichoderma atroviride ID20G inoculation ameliorates drought stress-induced damages by improving antioxidant defence in maize seedlings. Acta Physiol. Plant 2016, 38, 132. [Google Scholar] [CrossRef]
- Scudeletti, D.; Crusciol, C.A.C.; Bossolani, J.W.; Moretti, L.G.; Momesso, L.; Servaz Tubaña, B.; de Castro, S.G.Q.; de Oliveira, E.F.; Hungria, M. Trichoderma asperellum inoculation as a tool for attenuating drought stress in sugarcane. Front. Plant Sci. 2021, 12, 570. [Google Scholar] [CrossRef]
- Mierek-Adamska, A.; Kotowicz, K.; Goc, A.; Boniecka, J.; Berdychowska, J.; Dąbrowska, G.B. Potential involvement of rapeseed (Brassica napus L.) metallothioneins in the hydrogen peroxide-induced regulation of seed vigour. J. Agron. Crop Sci. 2019, 205, 598–607. [Google Scholar] [CrossRef]
- Gravel, V.; Antoun, H.; Tweddell, R.J. Growth stimulation and fruit yield improvement of greenhouse tomato plants by inoculation with Pseudomonas putida or Trichoderma atroviride: Possible role of indole acetic acid (IAA). Soil. Biol. Biochem. 2007, 39, 1968–1977. [Google Scholar] [CrossRef]
- Hrynkiewicz, K.; Ciesielska, A.; Haug, I.; Baum, C. Ectomycorrhiza formation and willow growth promotion as affected by associated bacteria: Role of microbial metabolites and use of C sources. Biol. Fertil. Soils 2010, 46, 139–150. [Google Scholar] [CrossRef]
- Wood, P.J. Specificity in the interaction of direct dyes with polysaccharides. Carbohydr. Res. 1980, 85, 271–287. [Google Scholar] [CrossRef]
- Strzelczyk, E.; Szpotański, T. Cellulolytic and pectolytic activity of streptomycetes isolated from root-free soil, rhizosphere and mycorrhizosphere of pine (Pinus sylvestris L.). Biol. Fertil. Soils 1989, 7, 365–369. [Google Scholar] [CrossRef]
- Chomczynski, P.; Sacchi, N. Single-step method of RNA isolation by acid guanidinium thiocyanate-phenol-chloroform extraction. Anal. Biochem. 1987, 162, 156–159. [Google Scholar] [CrossRef] [PubMed]
- Marone, M.; Mozzetti, S.; De Ritis, D.; Pierelli, L.; Scambia, G. Semiquantitative RT-PCR analysis to assess the expression levels of multiple transcripts from the same sample. Biol. Proced. Online 2001, 3, 19–25. [Google Scholar] [CrossRef]
- Hammer, Ø.; Harper, D.A.T.; Ryan, P.D. PAST: Paleontological statistics software package for education and data analysis. Palaeontol. Electron. 2001, 4, 9. [Google Scholar]

| Strain | Pigmentation of Mycelium | Concentric Rings | Coconut Smell | Conidiophore Agglomeration | Shape of Conidia |
|---|---|---|---|---|---|
| TvI | Yellow-green-white | + | - | + | Spherical |
| TvII | White | - | + | - | Elliptical |
| TvIII | White | - | + | - | Spherical |
| TvIV | White | - | - | - | Spherical |
| TvV | Yellow-green-white | + | + | + | Spherical |
| TvVI | Yellow-green-white | + | - | + | Spherical |
| TvVII | Dark green | - | - | + | Spherical |
| Strain | Root [cm] | Hypocotyl [cm] | Fresh Biomass [mg] | Dry Biomass [mg] |
|---|---|---|---|---|
| C | 1.8 ± 0.2 b | 2.6 ± 0.2 a | 39.22 ± 1.48 c | 3.84 ± 0.63 b |
| TvI | 2.5 ± 0.2 a | 3.2 ± 0.2 a | 36.78 ± 1.25 c | 3.55 ± 0.09 b |
| TvII | 2.4 ± 0.2 a | 3.9 ± 0.2 a | 41.52 ± 1.34 c | 3.70 ± 0.13 b |
| TvIII | 1.9 ± 0.1 b | 1.7 ± 0.1 b | 34.06 ± 0.81 c | 4.03 ± 0.09 b |
| TvIV | 2.2 ± 0.1 b | 1.6 ± 0.1 b | 32.53 ± 1.12 c | 3.63 ± 0.12 b |
| TvV | 2.2 ± 0.2 b | 3.4 ± 0.2 a | 43.06 ± 1.47 c | 3.80 ± 0.17 b |
| TvVI | 2.3 ± 0.2 a | 3.1 ± 0.2 a | 50.72 ± 1.86 a | 4.53 ± 0.86 a |
| TvVII | 2.6 ± 0.2 a | 3.5 ± 0.3 a | 43.58 ± 1.09 b | 4.63 ± 0.10 a |
| Motif | Genes and the Number of Elements | Function | |
|---|---|---|---|
| BnMT | TC-rich repeats | BnMT1 (1), BnMT3 (1) | Defense and stress responsiveness |
| W box (TTGACC) | BnMT1 (1), BnMT2 (1), BnMT3 (2) | WRKY binding site involved in wounding and pathogen response | |
| CGTCA-motif | BnMT2 (1), BnMT3 (4) | MeJA responsiveness | |
| TGACG-motif | BnMT2 (1), BnMT3 (4) | ||
| TCA-element (CCATCTTTTT) | BnMT1 (1), BnMT2 (1) | SA responsiveness | |
| TCA (TCATCTTCAT) | BnMT3 (3) | ||
| as-1 (TGACG) | BnMT2 (1), BnMT3 (4) | ||
| BnRSH | AT-rich sequence | BnCRSH (1) | Fungal elicitor-mediated activation |
| TC-rich repeats | BnCRSH (2) | Defense and stress responsiveness | |
| W box (TTGACC) | BnRSH1 (1), BnRSH3 (1) | WRKY binding site involved in wounding and pathogens response | |
| CGTCA-motif | BnRSH2 (2), BnRSH3 (3), BnCRSH (4) | MeJA responsiveness | |
| TGACG-motif | BnRSH2 (2), BnRSH3 (3), BnCRSH (4) |
| Gene/Gene ID | Primer Sequences 5′-3′ | Size of PCR Product (bp) | Temperature of Annealing | Number of PCR Cycles |
|---|---|---|---|---|
| BnMT1 JX035784.1 | for TGGCAGGTTCTAACTGTGGA rev CAAATGAAAACATTATACACCACACA | 309 | 52 °C | 30 |
| BnMT2 JX103200.1 | for TCAATTTGATTAAATTCTCTGCT rev AAGCCTGCAGCCATTATTACA | 401 | 52 °C | 30 |
| BnMT3 JX103201.1 | for GCAAAACAACAAAACACACACA rev CTCACGCTATCCTCCGTCTC | 418 | 56 °C | 26 |
| BnRSH1 XM_013821537.3 | for GGAGGTTCAGATCAGAACCG rev CCATTCACCTTCGCTGCTAC | 396 | 58 °C | 32 |
| BnRSH2 XM_022703426.2 | for GCAAGATGTTGAAGAAGAATCTAACG rev GCACAGACATCTTGTCATTTTCG | 534 | 54 °C | 34 |
| BnRSH3 XM_048781742.1 | for CCGAAACTTTCCGATTTCAA rev TCGTAGTCAACGCACGAGTC | 524 | 54 °C | 34 |
| BnCRSH XM_048753141.1 | for AAGTGATGGAGGAGCTTGGA rev CCATTTACTGGAACGCAACA | 263 | 54 °C | 38 |
| BnAct NM_001316010.1 | for CTCACGCTATCCTCCGTCTC rev TTGATCTTCATGCTGCTTGG | 469 | 52 °C | 30 |
| Month | I Decade [mm] | II Decade [mm] | III Decade [mm] | Sum [mm] |
|---|---|---|---|---|
| April | 10.6 | 13.2 | 0.7 | 24.5 |
| May | 2.2 | 6.7 | 16.5 | 25.4 |
| June | 8.6 | 23.5 | 7.4 | 39.5 |
| July | 27.6 | 9.2 | 6.1 | 42.9 |
Disclaimer/Publisher’s Note: The statements, opinions and data contained in all publications are solely those of the individual author(s) and contributor(s) and not of MDPI and/or the editor(s). MDPI and/or the editor(s) disclaim responsibility for any injury to people or property resulting from any ideas, methods, instructions or products referred to in the content. |
© 2023 by the authors. Licensee MDPI, Basel, Switzerland. This article is an open access article distributed under the terms and conditions of the Creative Commons Attribution (CC BY) license (https://creativecommons.org/licenses/by/4.0/).
Share and Cite
Garstecka, Z.; Antoszewski, M.; Mierek-Adamska, A.; Krauklis, D.; Niedojadło, K.; Kaliska, B.; Hrynkiewicz, K.; Dąbrowska, G.B. Trichoderma viride Colonizes the Roots of Brassica napus L., Alters the Expression of Stress-Responsive Genes, and Increases the Yield of Canola under Field Conditions during Drought. Int. J. Mol. Sci. 2023, 24, 15349. https://doi.org/10.3390/ijms242015349
Garstecka Z, Antoszewski M, Mierek-Adamska A, Krauklis D, Niedojadło K, Kaliska B, Hrynkiewicz K, Dąbrowska GB. Trichoderma viride Colonizes the Roots of Brassica napus L., Alters the Expression of Stress-Responsive Genes, and Increases the Yield of Canola under Field Conditions during Drought. International Journal of Molecular Sciences. 2023; 24(20):15349. https://doi.org/10.3390/ijms242015349
Chicago/Turabian StyleGarstecka, Zuzanna, Marcel Antoszewski, Agnieszka Mierek-Adamska, Daniel Krauklis, Katarzyna Niedojadło, Beata Kaliska, Katarzyna Hrynkiewicz, and Grażyna B. Dąbrowska. 2023. "Trichoderma viride Colonizes the Roots of Brassica napus L., Alters the Expression of Stress-Responsive Genes, and Increases the Yield of Canola under Field Conditions during Drought" International Journal of Molecular Sciences 24, no. 20: 15349. https://doi.org/10.3390/ijms242015349
APA StyleGarstecka, Z., Antoszewski, M., Mierek-Adamska, A., Krauklis, D., Niedojadło, K., Kaliska, B., Hrynkiewicz, K., & Dąbrowska, G. B. (2023). Trichoderma viride Colonizes the Roots of Brassica napus L., Alters the Expression of Stress-Responsive Genes, and Increases the Yield of Canola under Field Conditions during Drought. International Journal of Molecular Sciences, 24(20), 15349. https://doi.org/10.3390/ijms242015349

